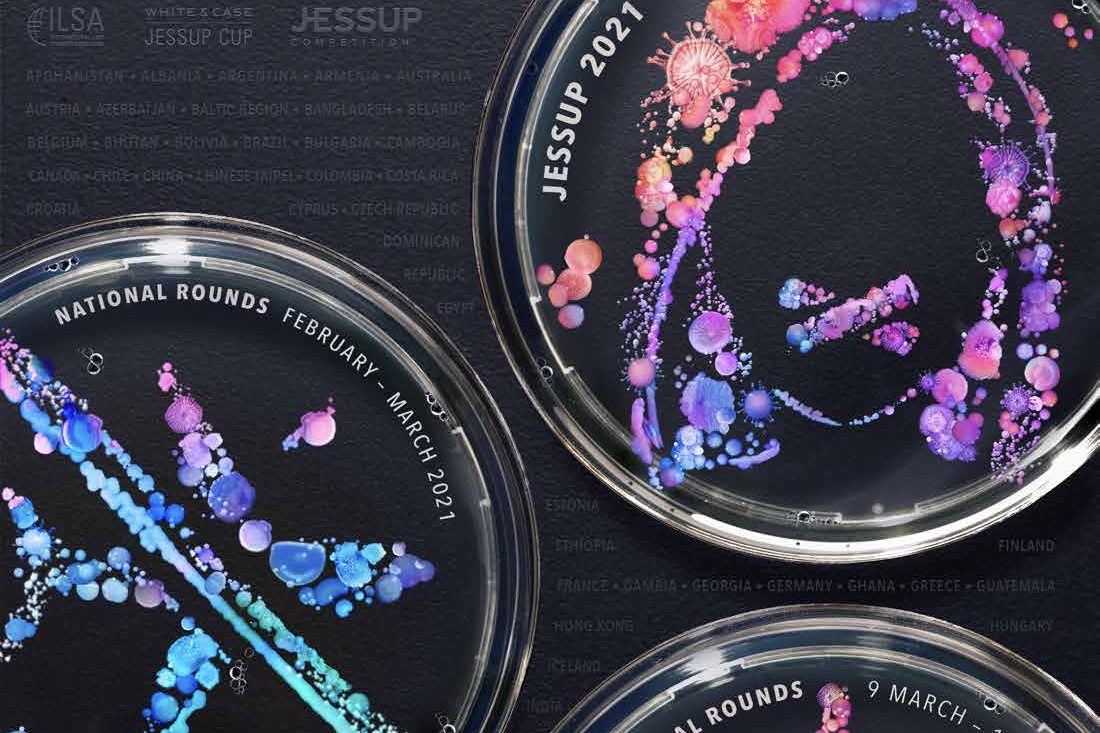

Call for Contributions: Dialing Into Jessup
Challenges and Lessons from a Digital Moot Court
The 2021 Jessup season is in full swing with national competitions being carried out these weeks and the International Rounds just around the corner. This year differs significantly from past competitions: Due to the COVID-19 pandemic the Jessup Moot Court is carried out in a fully digital mode. Teams, judges and administrators are organizing, pleading, deliberating and celebrating their victories physically separated from each other but connected virtually. What is more, all teams will have the opportunity to compete in the International Rounds without having to qualify through national competitions first.
The Jessup is the oldest and largest international moot court. Traditionally, national rounds are held in each participating country with the best teams advancing to the International Rounds in Washington, D.C. These circumstances have always lead to unevenly distributed challenges among participants. Visa requirements, travel restrictions and travel costs present greater obstacles for some teams more than for others. Access to literature and dedicated coaching varies significantly between teams from different countries but also among teams from the same country but from different universities. And how international was the international moot court for those teams that competed only in the national rounds anyway?
On the occasion of this extraordinary Jessup year, Völkerrechtsblog would like to ask which challenges and opportunities arise from a completely digital moot court. Is the digital mode able to address and mitigate some of the asymmetries inherent in the traditional competition format? Should some elements of the digital Jessup be implemented in future competitions? And what does preparing for and competing in the digital Jessup mean especially for the team members whose regular curricula as students have been turned upside down by the pandemic?
If you are a coach, team, administrator or judge involved in the Jessup 2021 competition we would like to learn about your experiences and thoughts on the questions raised above. As we are aware that all efforts are still bound by the ongoing competition, we are proposing a two-step procedure: If you are interested in writing a short contribution on these questions, please indicate this to us via e-mail to editorial-team@voelkerrechtsblog.org by March 13, 2021 (Update: on a rolling basis until the end of the Global Rounds). In the e-mail, please also tell your role in this year’s competition (coach, team, judge, administrator), from which part of the world you are participating and a short indication about the focal point(s) of your planned contribution (1-2 sentences). In a second step, we would ask you to send us your contribution (around 1500 words) by the end of April 2021.

Alicia is a PhD Candidate at Humboldt-Universität zu Berlin and a Law Clerk at Kammergericht Berlin. Her fields of interest include Public International Law and International Investment Law. She is the co-editor of the recently published edited volume “Cynical International Law?” (Springer, 2020).